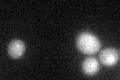
YLR183C
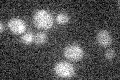
YLR183C

View description
Forkhead Associated domain containing protein and putative transcription factor found associated with chromatin; target of SBF transcription factor; expression is periodic and peaks in G1; similar to PLM2
Localization:
Intensity:
Fold change:
Significance:
-
C’ GFP library in SD

nucleus:cytosol17.57 -
N' NOP1pr-GFP in SD

nucleus48.4773 -
N' TEF2pr-mCherry in SD

cytosol,nucleus20.5406 -
N' NATIVEpr-GFP in SD

nucleus22.0601 -
N' TEF2pr-VC and Cyto-VN in SD

#N/A0 -
C’ GFP library in SD+DTT
nucleus.cytosol19.491.1No -
C’ GFP library in SD+H2O2

nucleus.cytosol16.80.95No -
C’ GFP library in Starvation Media
nucleus,cytosol14.790.84No -
C’ GFP library on the background of Pup2-DaMP

nucleus:cytosol -
C’ GFP library on the background of CCT mutant

nucleus:cytosol16.47120.936545No
